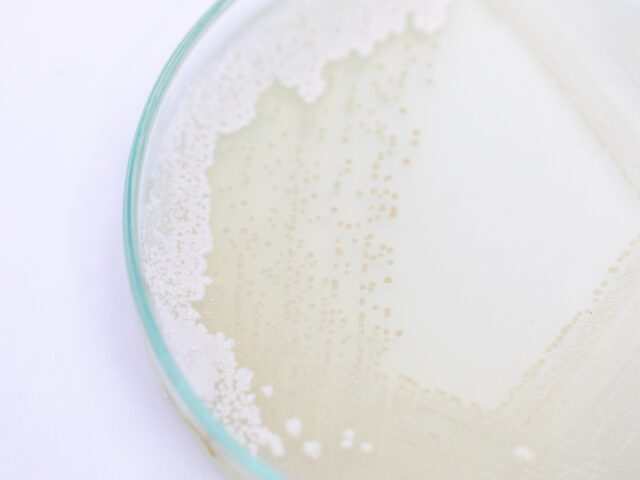

Blog
Najważniejsze etapy produkcji mleka
Mleko musi spełniać wszystkie normy dotyczące jakości. Większość osób kupując je w sklepie, nie zdaje sobie sprawy z tego jak...
Jak badać mleko we własnym zakresie?
Czy warto badać mleko na własną rękę? Próbki surowego mleka mogą zostać zbadane przez wyspecjalizowane laboratoria lub przez...
Analizatory do mleka. Czym są I jak działają?
Analizatory mleka do badania składu i wykrywania antybiotyków Analizatory mleka służą do wykonywania analiz jakościowych i badań...
Kultury bakterii w twarogu
Twaróg należy do najzdrowszych przetworów mlecznych. Choć ma stosunkowo niską zawartość wapnia, jest bogatym źródłem...
Dlaczego mleko poddaje się analizie?
Mleko surowe w przemyśle mleczarskim poddawane jest analizom mikrobiologicznym, cytologicznym i biochemicznym. Ich celem jest...
Wartości odżywcze mleka
W skład mleka wchodzi nie tylko budujący kości wapń, lecz również wiele innych witamin i pierwiastków mineralnych, regulujących...
Jak dobrostan bydła przekłada się na jakość mleka?
Dobrostan bydła, czyli zaspokojenie jego podstawowych potrzeb fizycznych i psychicznych, ma olbrzymi wpływ na jakość mleka....
Polskie normy dotyczące jakości mleka
Polskie normy dotyczące jakości surowego mleka, oddawanego do skupu przez rolników, są mocno wyśrubowane. Mleko, pochodzące od...
Po czym poznać jakość mleka?
Jakość mleka poznaje się przede wszystkim po tym, czy zawiera ono w swoim składzie antybiotyki. Sprawdź, jakie testy pozwolą je...
Charakterystyka inkubatorów do mleka
Mleko krowie mimo licznych kontrowersji wciąż zajmuje istotne miejsce w diecie człowieka. Jeśli nie pijemy samego mleka, to...
Zasady doboru kultur mleczarskich
Mleko to wciąż ważny składnik diety wielu osób. Znajduje ono uznanie jako napój – w swej niezmiennej postaci, poddane jedynie...
Jakie standardy muszą spełniać powłoki do sera?
Powłoki do sera pełnią szereg ważnych funkcji. Ich zadaniem jest ochrona sera przed różnymi czynnikami. Przede wszystkim jest...
Na czym polega bioprotekcja mleka?
Na czym polega bioprotekcja mleka? Nawet osobom, które niezwiązane są z branżą mleczarską, zdarzało się usłyszeć zwrot...
Jakie mleko jest uznawane za zdrowe?
Chociaż od kilku lat trwają dyskusje o tym, czy mleko krowie ma rzeczywiście wartość dietetyczną dla człowieka, wciąż...
Czym leczyć krowę?
Na mastitis, czyli schorzenie gruczołu mlekowego co roku choruje około 20-50% krów w Polsce. Wiele mówi się o tym, że w...